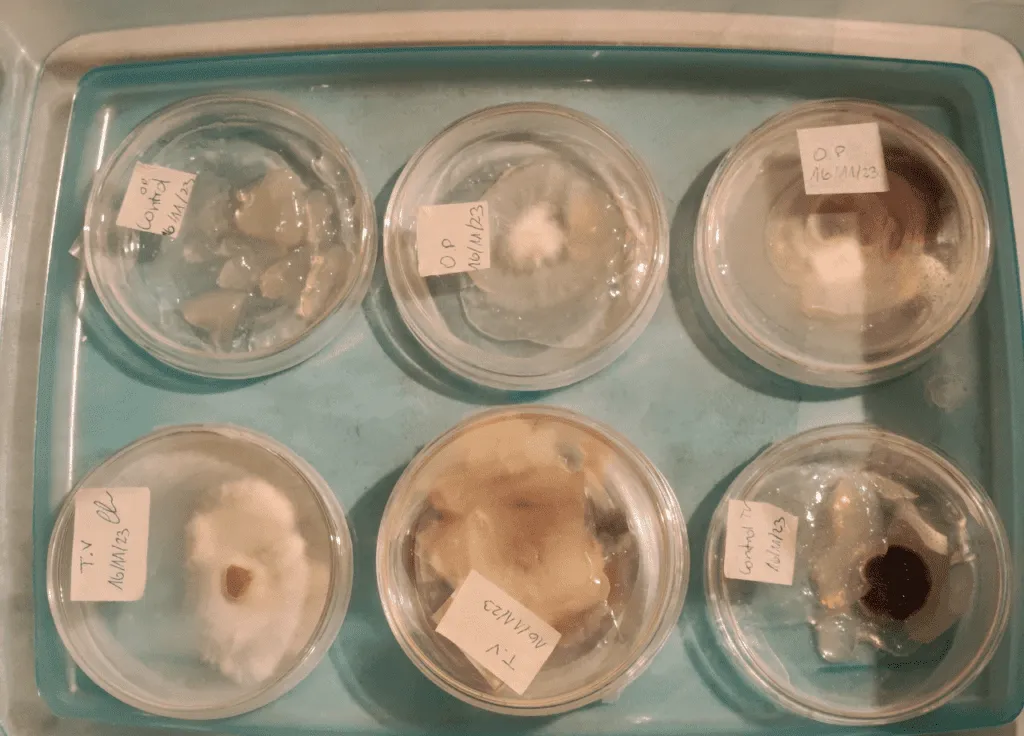
Hongos, corontas y algas: Los biomateriales que desarrolla la UTEM para la construcción

Temuco en ascenso: Nuevo referente de inversión y calidad de vida que redefine el sur de Chile
Temuco, la vibrante capital de la Región de La Araucanía, se consolida como uno de los destinos más promisorios de Chile, viviendo una transformación impulsada por un crecimiento económico robusto, inversiones estratégicas en infraestructura y una notable valorización de su mercado inmobiliario.